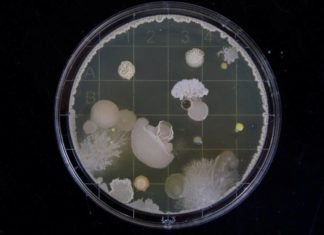
DARPA создает бактерии, умеющие улавливать взрывные устройства

Космический объект под названием Оумуамуа, который был обнаружен и зарегистрирован в 2017 году в качестве первого космического объекта, пролетающего через нашу Солнечную систему, представляет собой настоящую загадку для исследователей. Некоторое время тому назад отдельная команда специалистов из нескольких университетов США даже высказывала мнение о том, что объект потенциально может представлять собой нечто вроде спутника-обсерватории внеземных цивилизаций, однако такая теория пока что уступает в правдоподобности той, которая оглашает Оумуамуа в качестве необычного астероида. Хотя, конечно, правда, как всегда, где-то неподалеку.
Сегодня команда астрономов из Обсерватории Халеакака, расположенной на территории Гавайского Университета, сообщила широкой общественности о том, что дополнительные наблюдения за объектов – который официально именуется в качестве 1I/2017 U1 – показали, что скорее всего он представляет собой нечто среднее между астероидом и кометой. На это указывает весьма необычный паттерн его движения и не менее необычная форма в виде вытянутой сигареты.

Дело в том, что объект Оумуамуа двигается по необычной траектории, слегка совершая орбитальное вращение и, по-видимому, не обращая особенного внимания на маленькие источники радиации и гравитационной силы вокруг себя. Предполагается, что объект в большей степени является частью некогда значительно более крупного астероида, который в свое время подвергся воздействию другого астероида либо кометы – в результате чего Оумуамуа выглядит и движется столь необычным образом. Впрочем, эти предположения пока так и остаются предположениями специалистов.
Другие команды исследователей активно спорят с этой позицией и полагают, что на самом деле Оумуамуа является частью значительно более маленького по размеру объекта, нежели огромный астероид, и происходит из весьма отдаленной галактики – которая, потенциально, прошла через соединение с другой смежной галактикой, что также отчасти может объяснять необычную природу и формат объекта.